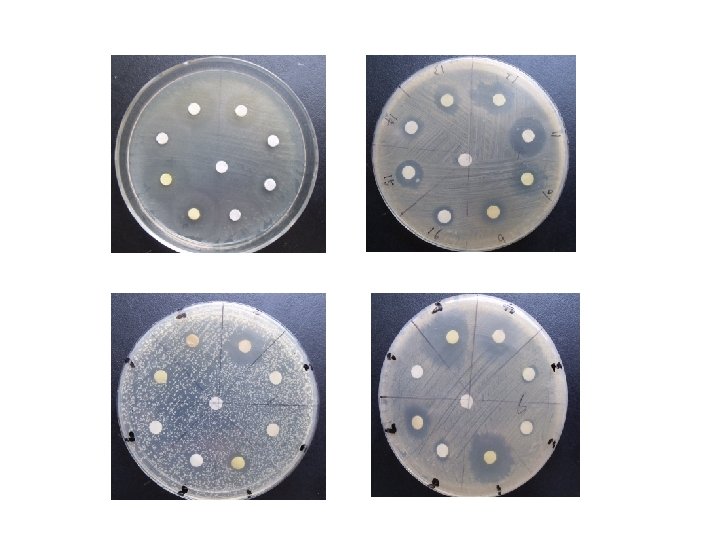

ISAPP 2014 Annual Meeting Indigenous microbiota The technologies



国际会议 ISAPP 2014 Annual Meeting

Indigenous microbiota The technologies of metagenomics and metabolomics are broadening our knowledge of the roles the human gut microbiota play in health and disease.

Three types of intestinal bacterium > Bifidobacterium > Lactobacillus etc. > Streptococcus > Bacteroides etc. 双歧杆菌,乳酸杆菌等 �球菌,�杆菌等 菌等 Beneficial bacterium Opportunistic bacterium Harmful bacterium 有益菌 机会性致病菌 有害�菌 ØBeneficial for host animal. Ø�宿主有益. >Enterobacteriac (E. Coli,Salmonella etc. ) > clostridium etc. �杆菌(大�杆菌,沙�氏菌)梭 ØNormally not harmful. Ø一般情况下无害 ØHarmful for host animal. ØCause diarrhea and disease. Ø�宿主有害 Ø引起腹泻和疾病 Predominance of Beneficial bacterium keeps good condition inside intestine 有益菌保持�道健康起主�作用。



• Activities of the gut microbiota are now known to play a central role in host energy requirements • Some functional foods are supplemented with probiotics, Lactobacilli and bifidobacteria are currently the most marketed probiotic bacteria worldwide.

(many foodborne pathogens) Depiction of the beneficial roles of probiotics in the mammalian gastrointestinal tract Ig. A, immunoglobulin A; TLR, Toll-like receptor.

Other types of Bifidobacterium 双歧杆菌的种� Infant Adult Monkey Dog Pig Chicken Cattle Sheep Mouth Honey bee B. bifidum ★ ★ B. longum ★ ★ B. infantis ★ B. brave ★ B. adolescentis ★ ● ● B. thermofilm ● ● ● B. pseudolongm ● ● ● B. animalis ● ● B. indicum ● B. astroides ● *B=Bifidobacterium



Representation of potential or proven effects of prebiotics in the intestinal tract

Selective stimulation of beneficial bacteria • • Fructo-oligosaccharides(FOS) Galacto-oligosaccharides (GOS) Arabino-oligosaccharides (AOS) Human milk oligosaccharides ( HMOs ) Inulin-type prebiotics

Inulin-Type Prebiotic Nomenclature

Composition of FOS 果寡糖(FOS)的�成 Fructoorigosaccharides (FOS) G F Sucrose 蔗糖 Enzyme 酶 G F F GF 2 G F F F GF 3 G F F GF 4 *As shown, FOS is composed of glucose combined with 1~3 fructoses. 如图所示,FOS是由一个蔗糖分子加上1 -3个果糖而构成的。


Microbiological changes reported in human feeding studies

The potential prebiotic properties of arabino-oligosaccharides (AOS) Healthy controls (white) Ulcerative colitis patients in remission (gray) Ulcerative colitis patients in relapse (black) Target genes encoded 16 S r. RNA

Sialic acid Structural features of human milk oligosaccharides ( HMOs )

L. Renee Ruhaak,2012,BMB Reports

determined using MALDI FTICR MS. Asterisks represents number of fucose residues on the specific oligosaccharide depicted by the mass/charge ratio (m/z). J Agric Food Chem. 2011

Depiction of the beneficial roles of prebiotics in the mammalian gastrointestinal tract and their systemic effects. Ca 2+, calcium; GLP-1, glucagon-like peptide-1; Gpr 41, G-protein coupled receptor 41; SCFA, short-chain fatty acid.




New functional ingredients


Metabolic Fate of Inulin-type Prebiotics

Enzymes of lactobacilli

Research of Microbial Bioactivity Metabolites

5 L FERMENTOR 13 L FERMENTOR 50 -500 L FERMENTOR


Microencapsulation Survival and activity of probiotics can be enhanced by encapsulation in the presence of prebiotics utilized by probiotics

- Slides: 37